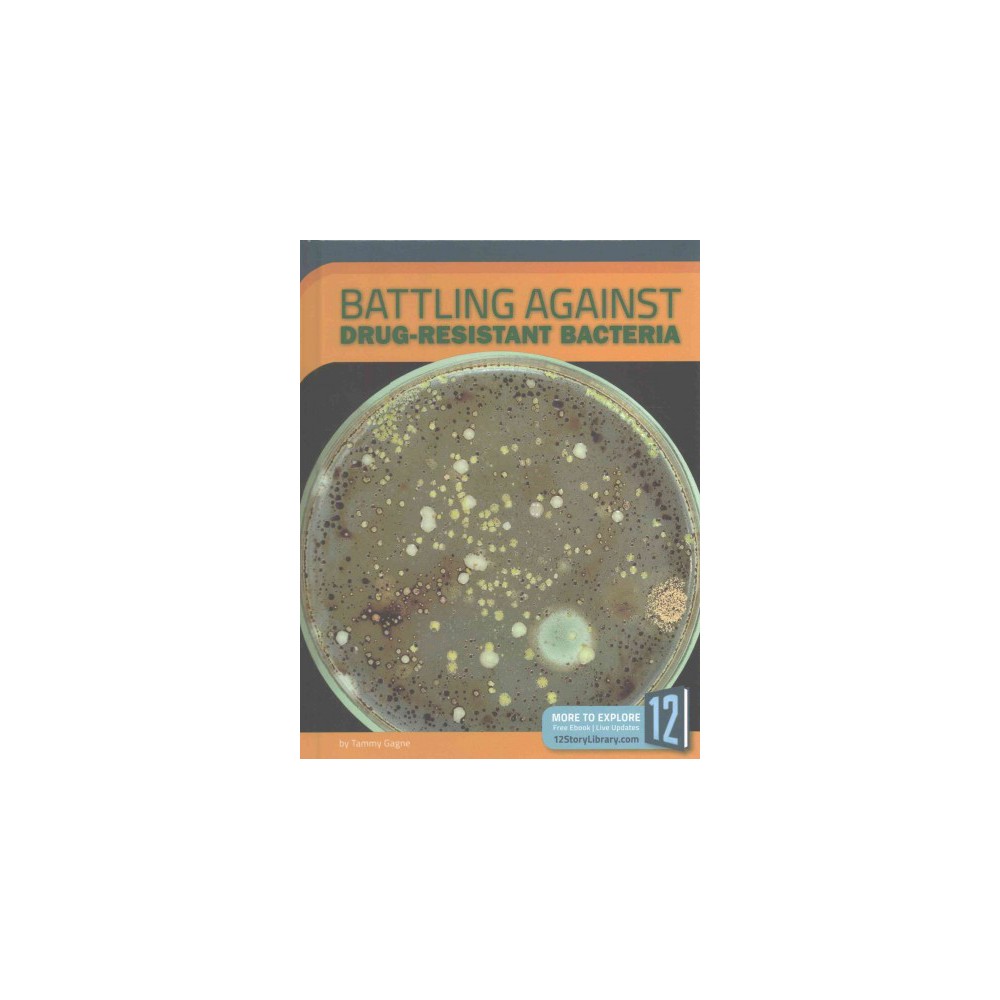

-
Frank Thorne's Battling Beauties (Hardcover)
Find Books at Target.com! Frank Thorne's Battling Beauties (Hardcover)
MPN: product_1444_51499241
-
Battling Brelyn (Paperback) (Mya Kay)
Find Books at Target.com! Battling Brelyn (Paperback) (Mya Kay)
MPN: product_1444_52198303
-
Suspicions ( Harlequin Intrigue: The Battling McGuire Boys) (Paperback)
Find Books at Target.com! Everyone's a suspect in New York Times bestselling author Cynthia Eden's latest book in The Battling McGuire Boys Mark Montgomery will never forget the night Ava McGuire galloped onto his ranch terrified out of her mind. Once he'd saved his best friend's sister from harm, the hardest part was letting her go. Now she's seeking safe haven againand rekindling desire that will engulf them both. Uncovering the truth about that long-ago night plunges Ava into a world where no one can be ...
MPN: product_1444_18772133
-
Isis : Battling the Menace (Paperback) (Patrick Cockburn)
Find Books at Target.com! Isis : Battling the Menace (Paperback) (Patrick Cockburn)
MPN: product_1444_51829613
-
Battling the Big Three (MP3-CD) (Doc Orman)
Find Books at Target.com! Battling the Big Three (MP3-CD) (Doc Orman)
MPN: product_1444_52066666
-
Battling Against Drug-resistant Bacteria (Library) (Tammy Gagne)
Find Books at Target.com! Battling Against Drug-resistant Bacteria (Library) (Tammy Gagne)
MPN: product_1444_51630656
-
Battling the Gods : Atheism in the Ancient World (Reprint) (Paperback) (Tim Whitmarsh)
Find Books at Target.com! Battling the Gods : Atheism in the Ancient World (Reprint) (Paperback) (Tim Whitmarsh)
MPN: product_1444_51816812
-
Battling Injustice : 16 Women Nobel Peace Laureates (Paperback) (Supriya Vani)
Find Books at Target.com! Battling Injustice : 16 Women Nobel Peace Laureates (Paperback) (Supriya Vani)
MPN: product_1444_51970607
-
Suspicions ( Harlequin Intrigue: The Battling McGuire Boys) (Larger Print) (Paperback)
Find Books at Target.com! Everyone's a suspect in New York Times bestselling author Cynthia Eden's latest book in The Battling McGuire Boys Mark Montgomery will never forget the night Ava McGuire galloped onto his ranch terrified out of her mind. Once he'd saved his best friend's sister from harm, the hardest part was letting her go. Now she's seeking safe haven againand rekindling desire that will engulf them both. Uncovering the truth about that long-ago night plunges Ava into a world where no one can be ...
MPN: product_1444_18772131
-
Carnival Games Pinata, Pinata
Find Party Supplies at Target.com! Item Includes: (1) themed pull-string pinata. Color: Multi-Colored. Gender: Unisex.
MPN: product_530_50656255
-
Devices of the Soul : Battling for Our Selves in an Age of Machines (Reprint) (Paperback) (Steve
Find Books at Target.com! Devices of the Soul : Battling for Our Selves in an Age of Machines (Reprint) (Paperback) (Steve
MPN: product_1444_53076767
-
Tank & Fizz : The Case of the Battling Bots (Paperback) (Liam O'Donnell)
Find Books at Target.com! Tank & Fizz : The Case of the Battling Bots (Paperback) (Liam O'Donnell)
MPN: product_1444_50378553



 $40.80
$40.80